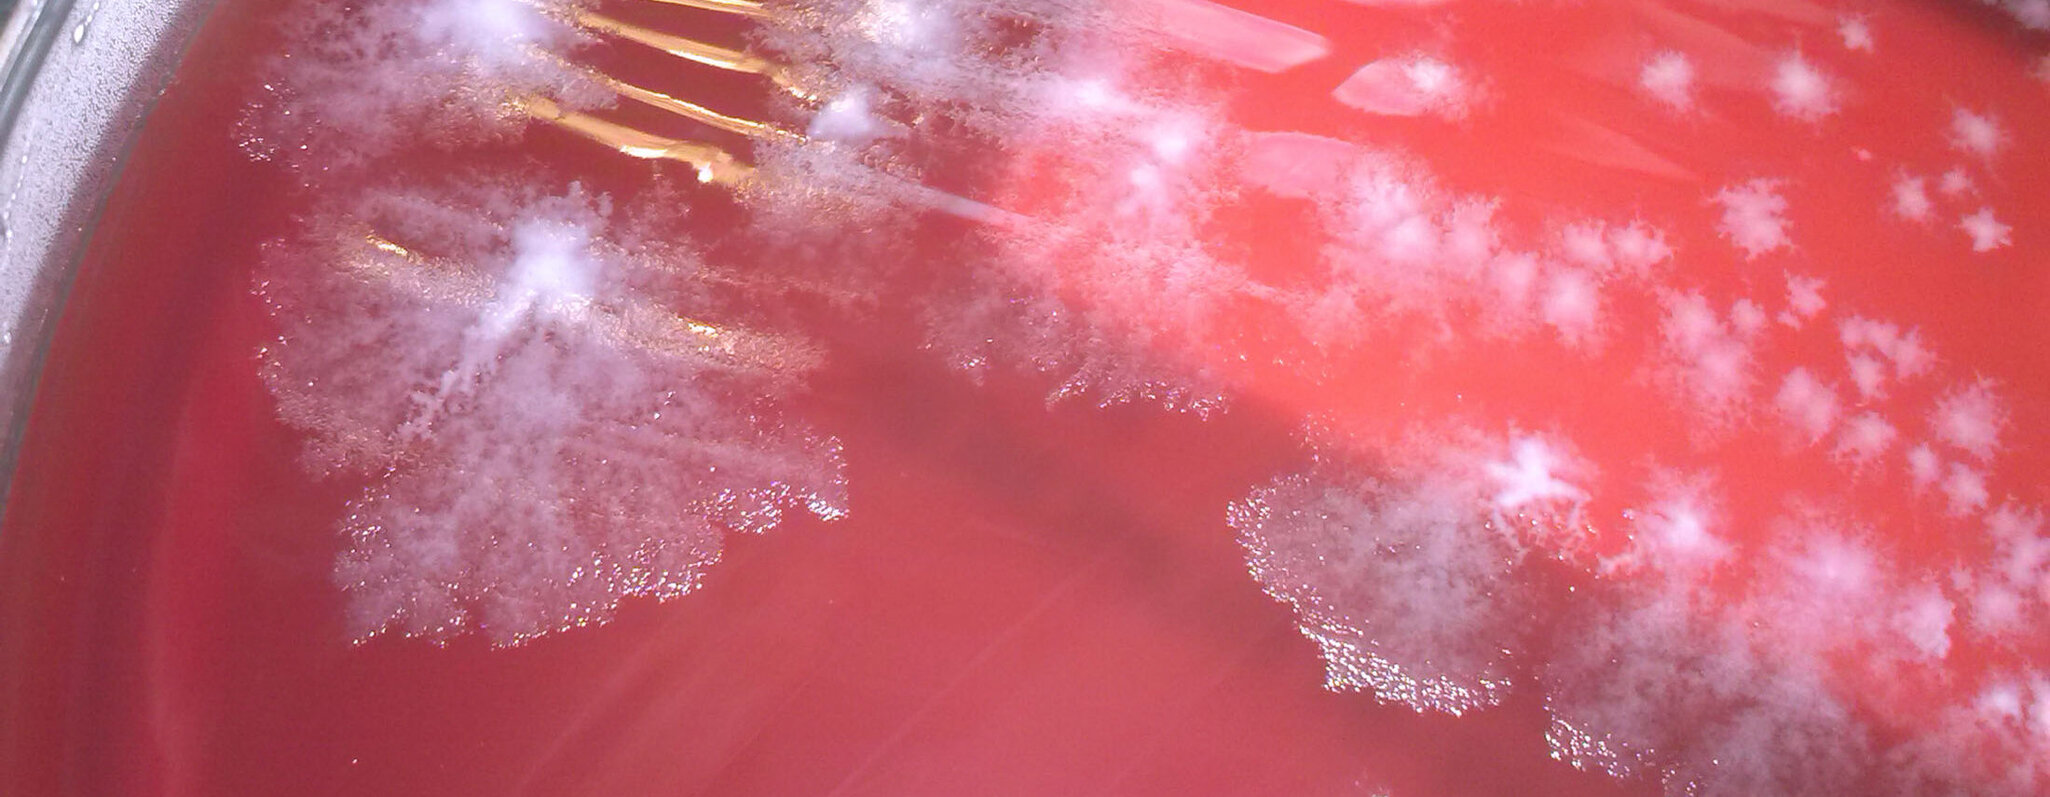

Nationales Referenzzentrum für Clostridioides (Clostridium) difficile am UKS
Das Universitätsklinikum des Saarlandes (UKS) bietet umfassende Unterstützung bei der Diagnostik, Therapie und dem Hygienemanagement im Zusammenhang mit Clostridioides difficile-Infektionen. Bei Clostridioides (Clostridium) difficile handelt es sich um eine Bakterienart, die schweren Durchfall und Darmentzündungen vor allem nach Antibiotikagabe verursacht. Das Nationale Referenzzentrum für Clostridioides (Clostridium) difficile ist Ansprechpartner für alle Fragen rund um diesen Erreger.

Kontakt & Ansprechpersonen

Leitungs-Team
Prof. Dr. Markus Bischoff
Prof. Dr. Barbara Gärtner
Prof. Dr. Alexander Mellmann
Prof. Dr. Lutz von Müller
Leistungsübersicht Nationales Referenzzentrum für Clostridioides (Clostridium) difficile am UKS
Folgende Leistungen bietet das Nationale Referenzzentrum für Clostridoides (Clostridium) difficile an
- Isolation des Erregers
- Empfindlichkeitsprüfung gegenüber therapeutisch oder epidemiologisch relevanten Substanzen
- Molekulare Subtypisierung incl. Ganzgenomsequenzierung im Rahmen von Ausbruchsuntersuchungen und zur Einordnung des Erregers in die globale Epidemiologie inc
- Bestimmung von Toxingenen und weiteren Resistenz- und Virulenzmarkern
- Beratung bei Problemfällen (Diagnostik, Therapie, Ausbruchsmanagement)
Die Untersuchung ist kostenlos für alle gemeldeten Fälle, zum Beispiel
- Ausbruchsuntersuchungen
- Schwere C.-difficile-Infektionen gemäß Meldepflicht
Für weitere Indikationen, die häufig auch kostenfrei durchgeführt werden, können Sie sich per E-Mail wenden an
Bei allen Einsendungen muss der Materialeinsendeschein ausgefüllt werden. Zudem muss die Meldepflicht nach §6 IfSG beachtet und der 2D-Barcode der DEMIS-Meldung an das Referenzzentrum weitergeleitet werden. Damit können unsere Typisierungsdaten direkt mit der Meldung verknüpft werden.
Diagnostik auf Clostridioides (Clostridium) difficile am UKS
Entsprechend den Leitlinien der European Society of Clinical Microbiology and Infectious Diseases (ESCMID) wird als Diagnostikalgorithmus zunächst ein Suchtest mit hoher Sensitivität wie Glutamatdehydrogenase (GDH) oder eine Polymerase-Ketten-Reaktion (PCR) zur Detektion des Toxin-B-Gens (cdtB) empfohlen (1). Zum Nachweis einer Toxinproduktion auf Proteinebene ist zusätzlich ein Test auf das Vorhandensein von Toxin mittels ELISA (Enzyme-linked Immunosorbent Assay) beziehungsweise CLIA (Chemilumineszenz-Immunoassay) oder eine toxigene Kultur empfehlenswert (1). Insbesondere der Toxinnachweis kann je nach Dauer zwischen Abnahme und Bearbeitung durch das Labor häufig falsch negativ ausfallen (2). Ein positiver Suchtest bei negativem Toxinnachweis sollte daher nicht die Therapie bei passender Klinik unnötig verzögern.
In manchen Fällen kann es sinnvoll sein, mit einem dritten Bestätigungsverfahren eine mögliche Infektion nachzuweisen (1). Bei einem Diagnostikalgorithmus zum Beispiel von GDH gefolgt von einer Toxinbestimmung kann eine PCR (oder die toxigene Kultur) zur Klärung bei negativem Toxinnachweis beitragen. Die Verlaufskontrollen sind rein klinisch, sodass Nachtestungen nicht sinnvoll sind. Auch die Testung asymptomatischer Patientinnen und Patienten ist nicht indiziert. Im Nationalen Referenzzentrum für Clostridioides (Clostridium) difficile ist die Typisierung von Isolaten schwerer gemeldeter klinischer Verläufe kostenlos.
Typisierung von C. difficile im NRZ
Es gab Rückfragen aus den Landesstellen zu den aktuellen Typisierungsmethoden von C. difficile und der damit verbundenen Nomenklatur. Mit der dynamischen Entwicklung von molekulargenetischen Methoden hat sich in den vergangenen Jahrzehnten auch die Genotypisierung von Bakterien verändert. Ausgehend Banden-basierten Methoden (z.B. Pulsfeld-Gelelektrophorese (PFGE)) entwickelten sich sequenzbasierte Methoden von single-locus-sequence-typing, SLST) über multiple-locus-sequence-typing (MLST) bis zur Ganzgenomsequenzierung. Mit der MLST konnten anders als bei früheren Typisierungsmethoden erstmals nicht nur Unterschiede zwischen Stämmen sondern auch genetische Verwandtschaften analysiert werden. Für die Genotypisierung von C. difficile wurden in den 2000er Jahren verschiedene Typisierungsmethoden nahezu gleichberechtigt eingesetzt: PFGE, das SLST (Surface-layer protein A, slpA), MLST, multiple-locus variable number of tandem repeats (MLVA) und die PCR-Ribotypisierung. International setzte sich die Ribotypisierung als Standardmethode durch, da sie besonders gut geeignet war die häufigsten Stämme einschließlich des neuen Hypervirulenten Ausbruchsstamms Ribotyp 027 (PFGE Muster NAP-1) zu identifizieren. Als einfache, Banden-basierte Methode kann aber mit der PCR-Ribotypisierung keine Verwandtschaft zwischen Stämmen berechnet werden und auch die Benennung und das Erkennen von neuen Ribotypen ist nur eingeschränkt möglich. Mit der ransanten Entwicklung neuer Sequenziermethoden wurde in den vergangenen Jahren die Ganzgenomsequenzierung für die Genotypisierung der gesamten Bakteriologie zum allgemeinen Goldstandard. Sie erlaubt die Einteilung in Verwandtschaftsbäume mit Claden, Sequenztypen (ST), cgMSLT sowie in der Charakterisierung einzelner Gene (Resistenzgene, Virulenzgene, etc.). Außerdem erlauben die sequenzbasierten Methoden den einfachen Austausch von Sequenzen als Basis für eine international einheitliche Nomenklatur, die die Nomenklatur der Banden-basierten Methoden einschließlich der Ribotypen ablösen. Für eine gewisse Übergangszeit wird es jedoch für die Verständigung hilfreich sein, wenn zusätzlich zu ST und cgMLST auch Ribotyp-Analoga aus den Genomsequenzen abgeleitet werden. Die meisten Ribotypen können aus Ganzgenomsequenzen abgeleitet werden, so dass die Ribotypisierung als Methode entbehrlich geworden ist. Nicht immer kann aber ein ST/cgMLST genau einem Ribotyp zugeordnet werden, was an der fehlenden verwandtschaftlichen Auflösung der „alten“ Ribotypisierung liegt. So gehört eine Gruppe von Ribotyp 027 Isolaten zum ST1, eine zweite zum ST417 – ohne direkte Verwandtschaft. Diese neue internationale Nomenklatur ist naturgemäß anders als die einfache Nomenklatur der Ribotypen. Die Ganzgenomsequenzierung ist allen anderen genetischen Typisierungsmethoden überlegen und basiert anders als die Banden-basierten Methoden auf einer verwandtschaftsbezogenen Nomenklatur.
Das NRZ hat mehr als 1 Jahr lang parallel Erfahrungen mit Ribotypisierung und Ganzgenomsequenzierung (WGS) gesammelt und die Überlegenheit der WGS einerseits und die Möglichkeit der Berechnung von Ribotyp-Analoga aus den Ganzgenomdaten gezeigt. Seit Januar 2024 erfolgt die Typisierung ausschließlich mittels WGS und nicht mit mehr durch die klassische Ribotypisierung. Die Befunde erlauben die Zuordnung von verwandtschaftsbezogenen ST/cgMLST, zu berechneten Ribotyp-Analoga mit denen der Bezug zum bisherigen Schrifttum hergestellt werden kann und darüber hinaus die charakterisierung von Virulenz- und Resistenzgenen (genotypische Resistenztestung).
Das NRZ C. difficile möchte damit den Bezug zur mittlerweile fast historischen Ribotyp Nomenklatur anbieten und gleichzeitig die moderne Seqenzcharakterisierung mit ihren vielfältigen neuen Anwendungen pflegen und weiterentwickeln.
Diese Technik erlaubt – im Gegensatz zur Ribotypisierung – nicht nur die Einordnung von Erregerisolaten in die (inter)nationale Epidemiologie, sondern ermöglicht mit einer hohen Auflösung auch die Beantwortung der Frage, ob sich bestimmte Erreger(klone) ausbreiten und Ausbrüche und schwere Erkrankungen verursachen. Zudem ist die Reproduzierbarkeit der Ganzgenomsequenzierung deutlich höher, sodass die Ribotypisierung zukünftig vollständig ersetzt wird. Aus historischen Gründen und weil sich die technische Weiterentwicklung in Richtung der Ganzgenomsequenzierung noch nicht international gleichermaßen durchgesetzt hat, wird die Ribotypisierung noch vielfach eingesetzt. Damit eine Rückwärtskompatibilität mit der Ribotypisierung möglich ist, hält das NRZ für ausgewählte Fälle noch die Ribotypisierung zur Verfügung; darüber hinaus entwickelt das NRZ ein Verfahren, um aus Genomsequenzdaten auch den Ribotyp abzuleiten.
Das NRZ bittet weiterhin um die Einsendung von Isolaten oder Stuhlproben, insbesondere bei Ausbrüchen oder meldepflichtigen schweren C. difficile-Fällen. Stuhlproben können auch nach Beginn einer Therapie entnommen und eingesandt werden.
Ausbruchsuntersuchungen
Wenn ein Clostridioides difficileAusbruch in einer Einrichtung vermutet wird, können nach telefonischer Rücksprache die Isolate zur (Sub-)Typisierung kostenfrei an das Referenzzentrum gesendet werden. Diese werden mittels verschiedener Methoden bis hin zur Ganzgenom-Sequenzierung weiter typisiert, um Verwandtschaftsverhältnisse aufzeigen zu können. Beachtet werden muss, dass ein Ausbruchsverdacht bereits meldepflichtig ist. Gerne beraten wir Sie ebenfalls zu hygienischen Maßnahmen im Ausbruchsfall.
Therapie bei einer Infektion mit Clostridioides (Clostridium) difficile
Die Empfehlungen des Referenzzentrums orientieren sich an den Leitlinien der ESCMID, die in Abbildung 1 zusammengefasst sind.
Kriterien für eine schwere C.-difficile-Infektion (CDI) sind
- Leukozytose (> 15 000/µL),
- Hypalbuminämie (< 30 g/L),
- Kreatinin-Erhöhung (> 1,5 mg/dL, alternativ > 1,5-facher Kreatinin-Anstieg im Vergleich zum Ausgangswert).
Risikofaktoren sind
- Alter über 65 Jahre
- Immunsuppression
- Komorbidität durch schwere Grunderkrankungen
- Dialyse
- frühere CDI

Folgende Punkte müssen beachtet werden
- Falls medizinisch vertretbar, soll die auslösende Antibiose abgesetzt werden. Einschränkung: Bei komplizierter Infektion mit C. difficile muss die begleitende Sepsis auch antibiotisch therapiert werden.
- Geänderte Bedeutung von Metronidazol:
- Früher wurde zur Therapie der CDI Metronidazol p.o. empfohlen obwohl es für die CDI nie eine Zulassungsstudie gab. Die Therapie mit Fidaxomicin p.o. (1. Wahl) oder Vancomycin p.o. (2. Wahl) ist jedoch überlegen und damit neuer Therapiestandard.
- Bei schweren Verläufen/Transportstörungen kann zur Therapieeskalation die orale Standardtherapie (Vancomycin oder Fidaxomicin) mit Metronidazol i.v. erweitert werden.
- Puls- und Reduktionsschemata mit Fidaxomicin sind bewährt, aber „off lable use“ (Dosierung entsprechend der EXTEND Study: Fünf Tage 2x200mg, dann 200mg jeden zweiten Tag (Tag 7-25), dies entspricht dem Ende der Packung). Diese gibt es auch für Vancomycin.
- Sollte kein Therapieerfolg innerhalb von drei Tagen eintreten, so muss die Diagnose CDI überprüft und weitere Differenzialdiagnosen erwogen werden.
- Nur wenige Zentren bieten die sog. Stuhltransplantation (Fäkaler Mikrobiomtransfer) in Deutschland an. Die Finanzierung der Spendertestung ist noch nicht geregelt.
- Von der FDA zugelassen, gibt es zwei kommerziell erhältliche Präparate die zum Fäkalien Mikrobiom Transfer verwendet werden können (Reyota oder Vowst) und über internationale Apotheke erhältlich sein sollten. Die sehr hohen Kosten sind zu beachten.
Hygienemaßnahmen bei Clostridioides (Clostridium) difficile
Durch die Fähigkeit von C. difficile zur Sporenbildung, stellt dieser Erreger eine Herausforderung für das Hygienemanagement dar. Die Sporen sind nicht durch die üblichen Händedesinfektionsmittel zu in aktivieren , sodass eine Handwaschung (nach erfolgter Händedesinfektion) zur Abreicherung der Sporen erfolgen muss. Das Umfeld der Patientin oder des Patienten sollte entsprechend mit sporoziden Desinfektionsmitteln aufbereitet werden. Patientinnen und Patienten im Krankenhaus sollten bis 48 Stunden nach Sistieren des Durchfalls isoliert werden. Eine Kohortenisolation ist möglich. Asymptomatische Personen mit Nachweis von C. difficile sind nicht zu isolieren.
Übersicht zu den gegenwärtigen RKI-Empfehlungen
Mitteilungen des VAH aus HygMed 3 2017
Empfehlung zur Auswahl sporizider Desinfektionsmittel bei Clostridium difficile-Infektionen im humanmedizinischen Bereich
Mitteilungen des VAH aus HygMed 1/2 2017
Mitteilung der Desinfektionsmittel-Kommission: Empfehlungen zur Auswahl sporizider Desinfektionsmittel bei Clostridium difficile-Infektionen im humanmedizinischen Bereich
Hyg Med 41. Jahrgang 2016
VAH-Testmethode zur Prüfung der Wirksamkeit gegenüber C. difficile veröffentlicht
(in HygMed 10/2016)
Epidemiologie der C. difficile-Infektion
Prinzipiell kann jeder toxigene Stamm schwere Verlaufsformen verursachen. Insbesondere im Krankenhaus sind die Ribotypen 001 (RT001) und RT027 weit verbreitet. RT027 ist ein Stamm, der ursprünglich aus Nordamerika stammt und erstmals im Jahr 2007 bei Ausbrüchen in Deutschland beschrieben wurde (1). Die Resistenz gegenüber Makroliden und Fluorchinolonen scheint hierbei einen wichtigen Selektionsfaktor darzustellen (2). Deutschlandweit gibt es gewisse regionale Prävalenzunterschiede, der einzelnen Subtypen (3,4,5). Darüber hinaus kann stets ein Eintrag weiterer Stämme aus dem Ausland erfolgen, wie dem RT018 (6) oder dem RT176 (7). Insbesondere RT027 und RT001 lassen sich maßgeblich durch Antibiotic Stewardship (rationaler Antibiotikaeinsatz mit Verminderung der „4C“-Antibiotika: Clindamycin, Fluorchinolone, Cephalosporine und Aminopenicilline mit Betalaktamaseinhibitor) zurückdrängen (8). Die untenstehende Abbildung gibt einen Überblick über die genotypischen Daten für die Jahre 2019 bis 2023, basierend aufsystematisch erhobenen Daten einer deutschlandweiten Prävalenzstudie .
Ribotypverteilung einer deutschlandweiten Prävalenzstudien

Ribotypverteilung einer deutschlandweiten Prävalenzstudien
- Vehreschild MJGT, Schreiber S, von Müller L, Epple HJ, Manthey C, Oh J, Weinke T, Wahler S, Stallmach A. Verbesserungsbedarf in der Versorgung von Patienten/-innen mit Clostridioides-difficile-lnfektionen (CDI) – Experten/-innenmeinung im internationalen Vergleich [Need for improvement in the care of patients with Clostridioides difficile infections (CDI) - expert opinion in international comparison]. Z Gastroenterol. 2024 Jul;62(7):1032-1041. German. doi: 10.1055/a-2293-7760. Epub 2024 Jul 8. PMID: 38976982.
- Blau K, Berger FK, Mellmann A, Gallert C. Clostridioides difficile from Fecally Contaminated Environmental Sources: Resistance and Genetic Relatedness from a Molecular Epidemiological Perspective. Microorganisms. 2023 Oct 5;11(10):2497. doi: 10.3390/microorganisms11102497. PMID: 37894155; PMCID: PMC10608975.
- Stallmach A, von Müller L, Storr M, Link A, Konturek PC, Solbach PC, Weiss KH, Wahler S, Vehreschild MJGT. Fäkaler Mikrobiota-Transfer (FMT) in Deutschland – Status und Perspektive [Fecal Microbiota Transfer (FMT) in Germany - Status and Perspective]. Z Gastroenterol. 2024 Apr;62(4):490-499. German. doi: 10.1055/a-2075-2725. Epub 2023 May 15. PMID: 37187187.
- Vehreschild MJGT, Schreiber S, von Müller L, Epple HJ, Weinke T, Manthey C, Oh J, Wahler S, Stallmach A. Trends in the epidemiology of Clostridioides difficile infection in Germany. Infection. 2023 Dec;51(6):1695-1702. doi: 10.1007/s15010-023-02044-5. Epub 2023 May 10. PMID: 37162717; PMCID: PMC10170422.
- Brestrich G, Angulo FJ, Berger FK, Brösamle C, Hagel S, Leischker A, Lübbert C, Maechler F, Merbecks SS, Minarovic N, Moïsi JC, von Müller L, Reuken PA, Weinke T, Yu H, Mellmann A. Epidemiology of Clostridioides difficile Infections in Germany, 2010-2019: A Review from Four Public Databases. Infect Dis Ther. 2023 Apr;12(4):1057-1072. doi: 10.1007/s40121-023-00785-2. Epub 2023 Mar 10. PMID: 36897556; PMCID: PMC10000342.
- Abdrabou AMM, Sy I, Bischoff M, Arroyo MJ, Becker SL, Mellmann A, von Müller L, Gärtner B, Berger FK. Discrimination between hypervirulent and non-hypervirulent ribotypes of Clostridioides difficile by MALDI-TOF mass spectrometry and machine learning. Eur J Clin Microbiol Infect Dis. 2023 Nov;42(11):1373-1381. doi: 10.1007/s10096-023-04665-y. Epub 2023 Sep 18. PMID: 37721704; PMCID: PMC10587247.
- Dirks EE, Luković JA, Peltroche-Llacsahuanga H, Herrmann A, Mellmann A, Arvand M. Molecular Epidemiology, Clinical Course, and Implementation of Specific Hygiene Measures in Hospitalised Patients with Clostridioides difficile Infection in Brandenburg, Germany. Microorganisms. 2022 Dec 22;11(1):44. doi: 10.3390/microorganisms11010044. PMID: 36677336; PMCID: PMC9862616.
- Effelsberg N, Buchholz M, Kampmeier S, Lücke A, Schwierzeck V, Angulo FJ, Brestrich G, Martin C, Moïsi JC, von Eiff C, Mellmann A, von Müller L. Frequency of Diarrhea, Stool Specimen Collection and Testing, and Detection of Clostridioides Difficile Infection Among Hospitalized Adults in the Muenster/Coesfeld Area, Germany. Curr Microbiol. 2022 Dec 16;80(1):37. doi: 10.1007/s00284-022-03143-6. PMID: 36526801; PMCID: PMC9757625.
- Abdrabou AMM, Bischoff M, Mellmann A, von Müller L, Margardt L, Gärtner BC, Berger FK; German C. difficile surveillance group. Implementation of a Clostridioides difficile sentinel surveillance system in Germany: First insights for 2019-2021. Anaerobe. 2022 Oct;77:102548. doi: 10.1016/j.anaerobe.2022.102548. Epub 2022 Mar 18. PMID: 35307546.
- Baktash A, Corver J, Harmanus C, Smits WK, Fawley W, Wilcox MH, Kumar N, Eyre DW, Indra A, Mellmann A, Kuijper EJ. Comparison of Whole-Genome Sequence-Based Methods and PCR Ribotyping for Subtyping of Clostridioides difficile. J Clin Microbiol. 2022 Feb 16;60(2):e0173721. doi: 10.1128/JCM.01737-21. Epub 2021 Dec 15. PMID: 34911367; PMCID: PMC8849210.
- D avies K, Davis G, Barbut F, Eckert C, Petrosillo N, Pisapia R, Reigadas E, Emilio Bouza, Berger F, Herrmann M, Wilcox MH: Multivariate analysis of factors affecting Clostridium difficile infection rates; the more you look, the more you find, but should you believe what you see?.
- Berger F, Bischoff M, Strauß C, von Müller L, Gärtner B.: Auftreten von Clostridium difficile Ribotyp 176 in Deutschland.
- Färber J, Illiger S, Berger F, Gärtner B, von Müller L, Lohmann C.H, Bauer K, Grabau C, Zibolka S, Schlüter D, Geginat G: Management of a Cluster of Clostridium difficile infections among patients with osteoarticular infections.
- Berger F: Clostridium difficile: Routine diagnostics in the medical laboratory.
- von Müller L.:Aktuelles zu Clostridium-difficile-Infektionen (New aspects on Clostridium difficile infection).
- Davies KA, Davis GL, Barbut F, Eckert C, Petrosillo N, Pisapia R, Reigadas-Ramirez E, Bouza E, Berger F, Herrmann M, Wilcox MH.: Seasonality of C. difficile Infection (CDI) Case Rates: Myth or Reality?.
- Davies KA, Davis GL, Barbut F, Eckert C, Spigaglia P, Barbanti F, Herrmann M, Berger F, Bouza E, Reigadas-Ramirez E, Wilcox MH.: Adverse outcomes for missed cases of CDI; results from retrospective data collection on patients with samples received during the EUropean, multi-centre, prospective bi-annual point prevalence study of CLostridium difficile Infection in hospitalised patients with Diarrhoea (EUCLID2).
- Weichert S, Simon A, von Müller L, Adam R, Schroten H.: Clostridium-difficile-assoziierte Infektionen im Kindes- und Jugendalter.
- S2k-Leitlinie Gastrointestinale Infektionen und Morbus Whipple.
- Tracing the Spread of Clostridium difficile Ribotype 027 in Germany Based on Bacterial Genome Sequences.
- Molecular and culture-based diagnosis of Clostridium difficile isolates from Côte d'Ivoire after prolonged storage at disrupted cold chain conditions.
- Combined stool-based multiplex PCR and microscopy for enhanced pathogen detection in patients with persistent diarrhoea and asymptomatic controls from Côte d'Ivoire.
- Epidemiology of Clostridium difficile in Germany based on a single center long-term surveillance and German-wide genotyping of recent isolates provided to the advisory laboratory for diagnostic reasons.
- Clostridium difficile infections among adults and children in Mwanza/Tanzania is it an underappreciated pathogen among immunocompromised patients in sub-Saharan Africa?
- Schwer verlaufende Clostridium-difficile-Infektionen: IfSG-Surveillancedaten von 2013.
- Detection of nosocomial Clostridium difficile infections with toxigenic strains despite negative toxin A and B testing on stool samples.
- Underdiagnosis of Clostridium difficile across Europe: the European, multicentre, prospective, biannual, point-prevalence study of Clostridium difficile infection in hospitalised patients with diarrhoea (EUCLID).